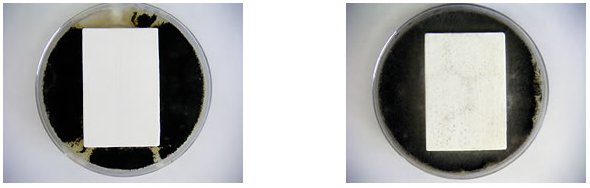
防カビ・防藻性

東進ホームはナノコンポジットWのパートナー会社です

ナノコンポジットWは、
ナノテクノロジーにより
「汚れにくい」
「色褪せしにくい」など、
6つの機能を驚異的に
向上させた
まったく新しい
水性高機能
エコ塗料
です
ナノコンポジットWが選ばれる理由
長持ち!
落ち着いた
質感!
対候性

無機成分と有機成分を
ナノレベルで複合し、
超低汚染性と耐久性を
両立した無機系塗料

ナノコンポジットWの6つの特徴

1.超低汚染性
汚れが雨で洗い流されます
(セルフクリーニング機能)
外壁汚れの原因物質は、ホコリ等の周りにばい煙等の油成分が付着したものです。
従来型塗料の場合、この「汚れ」が塗膜中に浸入・沈着し、洗浄しても除去できなくなってしまいます。
ナノコンポジットWの塗膜は、その中に無数の超微粒子シリカが緻密かつ均一に分散しているため、
無機質的な(石やガラスのような)特性を有しています。
これにより「汚れ」の浸入をブロックし、さらに降雨によりこの「弱く付着している汚れ」を洗い流します。
2.難燃性
酸素を遮断する融合膜が、「燃えにくさ」を実現
ナノコンポジットWの塗膜は燃えにくく、防火認定材料として認定されています。
万一火災が起きた場合でも、塗膜中に含まれる有機成分と無機成分が融合膜を形成し、酸素をシャットアウト。延焼を防ぎます。
従来型水性塗料では非常に難しいJISA1321難燃一級に合格しています。
NM-8585/不燃材料 QM-9816/準不燃材料 RM-9364/難燃材料

3.耐久性
ラジカル制御型樹脂によるナノレベルでの無機有機コンポジットが優れた耐久性を発揮
塗膜は紫外線や降雨により色や艶が劣化します。ナノコンポジットWは、紫外線や降雨に非常に強いシリコン化合物を塗膜中に導入すること(独自のリアルシリコンテクノロジー)により、色の劣化が最小限に抑えられています。(この特性は西表島暴露試験によって確認されており、JIS A 6909建築用仕上塗材で規定される複層仕上塗材の品質表示において、もっとも耐候性のある「耐候型1種」に匹敵しています。)

ラジカル制御技術=塗膜の長寿命化
ラジカルとは塗膜の劣化因子のことです。ワンランク上のラジカル制御、「ハイラジカル制御」により、塗膜の長寿命化が実現できました。
4.防カビ・防藻製
長期間にわたり、カビや藻を寄せ付けません
防カビ・防藻性とは、微生物の増殖を抑制する静菌作用と死滅させる殺菌作用の性能のことです。
ナノコンポジットW(左側)には防カビ・防藻剤が添加されていますので、右側の写真のようにカビ等が付着する状態を防ぎ、建物の美観を守ります。
5.速乾性
早く乾くので、ご近所への迷惑も最小限に
塗膜中に緻密かつ均一に分散したシリカ微粒子が水の蒸発を促進しますので、従来型水性塗料をはるかに凌ぐ速乾性を実現。また、水性ですので、溶剤のような刺激臭もありません。塗装工事の際のご近所への迷惑を最小限におさえることができます。
6.一液常温架橋による強靭な塗膜
ナノテクノロジーによる全く新しい架橋システムです。
シックハウスの心配をなくすフォースター
厚生労働省が規制するシックハウスの原因となる化学物質のうち、塗料・塗装関連のものについて、ホルムアルデヒドが規制対象となっています。
ナノコンポジットWは、ホルムアルデヒドの放散が最も少ない「F☆☆☆☆(フォースター)」を取得。シックハウスの心配をなくし、安全・安心な住環境を実現します。
※ナノコンポジット製品は、ナノコンポジットWの他、
「長持ち」と「汚れにくさ」の両立を追求した『ナノコンポジットF』、さらに防藻性を強化した『ナノコンポジットW防藻+(プラス)』があります。
詳しくはお問い合わせください。



